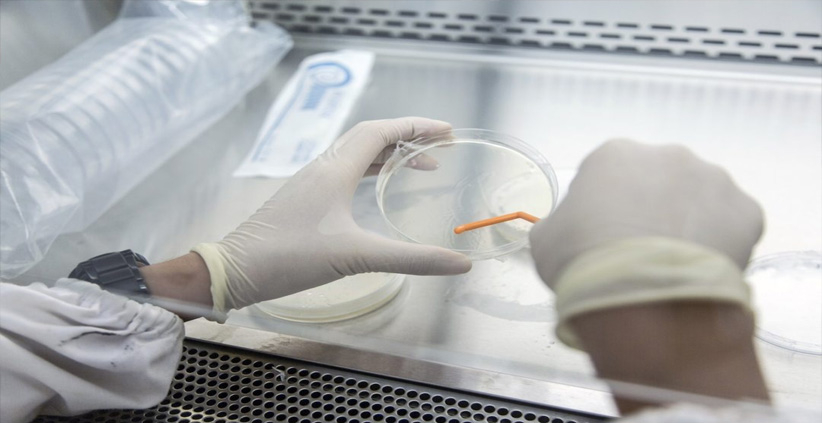
കോവിഡ് മഹാമാരിയേക്കാൾ 20 മടങ്ങ് മാരകം, 406 പേർ ചികിത്സ തേടി,143 മരണം; ഡീസീസ് എക്സിനെ കുറിച്ച് കൂടുതൽ

ഒരു അപൂർവ്വ രോഗത്തിന്റെ പിടിയിലമർന്ന് ഡെമോക്രാറ്റിക് റിപ്പബ്ലിക് ഓഫ് കോംഗോ. ഇൻഫ്ളുവൻസയോട് സാമ്യമുള്ള ഈ രോഗം വലിയ തോതിൽ അണുബാധയുള്ളതും മരണനിരക്ക് വർധിപ്പിക്കുന്നതുമായതുകൊണ്ട് ആളുകൾ ഭീതിയാലണെന്നാണ് വിവരം. ഈ കഴിഞ്ഞ ഒക്ടോബർ മുതൽ രാജ്യത്ത് 406 പേർക്ക് അസുഖം ബാധിച്ചിട്ടുണ്ട്.143 പേരാണ് മരണപ്പെട്ടത്. മരിച്ചവരിൽ ഭൂരിഭാഗവും കുട്ടികളാണെന്നതാണ് ആശങ്ക ഉയർത്തുന്ന കാര്യം. താരതമ്യേന രോഗപ്രതിരോധശേഷി കുറഞ്ഞ കുട്ടികളിലും പ്രായമായവരിലും രോഗബാധ വർദ്ധിക്കുന്നത് മരണസംഖ്യ ഇനിയും ഉയർത്തിയേക്കുമെന്നാണ് ആരോഗ്യവിദഗ്ധർ ആശങ്കപ്പെടുന്നത്.
പനി, തലവേദന, ചുമ, മൂക്കൊലിപ്പ്, ശരീരവേദന, ശ്വാസതടസം, വിളർച്ച ഇങ്ങനെയാണ് അസുഖബാധിതരിൽ കണ്ടെത്തിയ ലക്ഷണങ്ങൾ. മുൻ വർഷങ്ങിൽ പടർന്നുപിടിച്ച് പതിനായിരക്കണക്കിന് ആളുകളുടെ ജീവനെടുക്കുകയും നിരവധി പേരുടെ ജീവിതം തകർക്കുകയും ചെയ്ത കോവിഡ് മഹാമാരിയേക്കാൾ 20 മടങ്ങ് മാരകമാണ് ഈ ഡിസീസ് എക്സ് എന്നാണ് ലോകാരോഗ്യ സംഘടന മുന്നറിയിപ്പ് നൽകിയിരുന്നത്. 76ാമത് ആഗോള ആരോഗ്യസഭയിൽ അവതരിപ്പിച്ച റിപ്പോർട്ടിലാണ് ലോകാരോഗ്യസംഘടനയുടെ മേധാവിയായ ടെഡ്രോസ് അഥനോം ഗെബ്രിയേസുസ് ഈ കാര്യം വ്യക്തമാക്കിയിരുന്നത്.
കോംഗോയിൽ പടരുന്ന അജ്ഞാതരോഗത്തിൽ ആശങ്ക പ്രകടിപ്പിച്ച ലോകാരോഗ്യസംഘടന ഒരു വിദഗ്ധ സംഘത്തെ കോംഗോയിലേക്ക് അയച്ചിട്ടുണ്ട്. തിരിച്ചറിയപ്പെടാത്ത രോഗം എന്നാണ് ലോകാരോഗ്യ സംഘടന നിലവിൽ ഇതിനെ രേഖപ്പെടുത്തിയിരിക്കുന്നത് ലക്ഷണങ്ങൾ പ്രകാരം ഇത് ഡിസീസ് എക്സ് ആവാനാണ് സാധ്യത കൂടുതലെന്നും വിദഗ്ധർ പറയുന്നു.